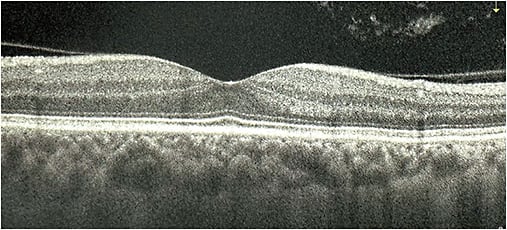
Figure 3. Vitreous opacities with incomplete paramacular PVD on optical coherence tomography (OCT).

DISSATISFACTION WITH VISION after cataract surgery with a presbyopia-correcting intraocular lens (PC-IOL) remains a challenging dilemma for both the patient and surgeon. Most commonly, the issue lies not with the PC-IOL itself but with other confounding factors related to erroneous IOL power selection, pre-existing pathology, and/or the patient’s own healing. Indeed, residual refractive error and ocular surface disease have been found to be the top causes of dissatisfaction after cataract surgery, especially with PC-IOLs.1,2 However, more recently, a third commonly overlooked factor has been found to have a more significant impact than previously thought—that is, the role of the vitreous.
Macromolecules, constituting a mere 2% of vitreous composition, play a crucial role in maintaining the eye’s gel-like consistency, transparency, and physiological functions. Age-related changes affect the interaction between collagen and hyaluronan, leading to simultaneous liquefaction of the gel and fibrous degeneration. This process often results in the collapse of the vitreous body during posterior vitreous detachment (PVD), causing the common visual phenomenon of vitreous opacities (VOs) or floaters. As the aggregated collagen fibers in the vitreous humor cast shadows on the retina, patients may notice gray circles or shadows obstructing certain areas of the vision following eye movement. While once considered harmless, these floaters can significantly impact vision by diminishing contrast sensitivity function and affecting quality of life. Clinically significant cases, termed vision degrading myodesopsia, can be diagnosed through echographic assessment and contrast sensitivity function measurements.3
Aside from natural aging, cataract patients may experience bothersome VOs after surgery due to an elevated incidence of PVD and increased perception of opacities in the improved visual field. Patients implanted with PC-IOLs, including multifocal and extended depth of focus (EDOF) IOLs, may be particularly sensitive to VOs due to the baseline reduced contrast sensitivity of these IOLs compared to monofocal IOLs.4 Small VOs, combined with overall diminished contrast sensitivity from larger VOs, can scatter light and exacerbate PC-IOL-related visual disturbances, impair distance vision and reading ability, including discernment of fine visual detail, and ultimately adversely affect daily visual function. While some patients may neuroadapt to VOs over time, others may continue to find them burdensome. This fact highlights the need for effective and accessible treatment options for pseudophakic patients with bothersome VOs.
Before any intervention, surgeons should confirm the diagnosis by evaluating the patient’s subjective complaints, as well as objective exam findings. Floaters can be difficult to quantify objectively, as the patient may present with 20/20 visual acuity but complain of generalized blurred vision. The key is to ascertain whether patients see a “film” or “fog” moving across their vision. Often, they will describe their vision as fluctuating in nature, and their vision may “clear up” as the opacity moves out of their central vision with their eyes’ changing gaze. Some patients will also describe seeing “cobwebs”, “strings”, or “strands” within their vision. On slit-lamp examination, VOs can be visualized in the anterior vitreous space as dense syneresis, veils, or strands, similar to the patients’ subjective descriptions. They can also be visualized and grossly quantified on optical coherence tomography, ultrasound, and fundus photography. Contrast sensitivity testing can be used to more objectively assess its visual impact and as a tool to quantify improvement following treatment.

Yttrium aluminum garnet (YAG) laser vitreolysis and pars plana vitrectomy (PPV) are the 2 most common methods for addressing symptomatic VOs. Studies have shown improved visual function and contrast sensitivity with YAG laser vitreolysis and PPV.5,6 Ophthalmologists should begin with patient counseling and education regarding the VO symptoms to discuss the risks and benefits in detail before considering interventions such as YAG laser vitreolysis or PPV for more severe cases.
YAG laser vitreolysis offers a quick and minimally invasive in-office procedure that surgeons can use to improve quality of vision in pseudophakic patients. While YAG laser has traditionally been used to treat posterior capsular opacities following cataract surgeries, it has recently been shown to also be effective in improving VO symptoms. During the procedure, the cataract surgeon targets the laser beam at the vitreous strands to vaporize or fragment the VOs into smaller pieces, which are less likely to be bothersome to the patient. Since the procedure is nonincisional, quick, and repeatable, surgeons can offer this intervention to significantly improve, but likely not completely eradicate, the patient’s symptoms. Patients who will experience the most improvement with YAG vitreolysis have a central, well-defined Weiss ring floater or focal cloud.7 YAG laser vitreolysis also represents a safer intervention, compared to the postoperative healing and risk of retinal detachment for patients who undergo PPV.
Souza et al utilized color fundus photographs to evaluate the efficacy of treating VOs with YAG laser and found that complete VO improvement was noted in 56.2% of eyes, partial improvement in 37.5% of eyes, and no change in 6.3% of eyes.8 The color fundus photograph represents an objective diagnostic technique to quantify the opacities, while considering the patient’s subjective complaints. Shah et al treated symptomatic Weiss ring floaters with YAG laser vitreolysis in a randomized, controlled trial and reported that 53% of the patients experienced improvement or resolution of floater symptoms.9 Specifically, for the PC-IOL population, I (DZ) presented my data at the ASCRS conference this year and showed that 75% of pseudophakic patients implanted with a trifocal or EDOF IOL achieved subjective improvement in their floater symptoms after a single YAG laser vitreolysis session.10 The majority of patients underwent only 1 session (55%) while a few required 4 or more (6.5%). In general, most treatments use laser beam energy between 2.5 and 6.5 mJ, with approximately 150 to 200 pulses needed to vaporize Weiss rings.8 However, the exact number of shots and amount of energy can range depending on the position and type of floater. Caution should be taken not to fire on the retina, and rare adverse events, including elevated intraocular hypertension, have been reported with a greater number of pulses. Overall, the existing literature has found YAG laser vitreolysis to be a safe and effective first-line treatment for symptomatic VOs, which can offer pseudophakic patients a primary nonsurgical option to address floater symptoms.

For patients with very bothersome and/or opaque VOs not improved with multiple YAG laser vitreolysis treatments, the cataract surgeon can consider referring the patient to a retina specialist for PPV. Small-gauge vitrectomy involves the removal of the eye’s vitreous humor and is the most definitive treatment for vitreous opacities. Nguyen et al evaluated the efficacy of PPV treatment across multifocal, monofocal, and phakic eyes and showed that while preoperative vitreous echodensity was the same in all lens cohorts, contrast sensitivity was worse in multifocal eyes, as one might expect.4 Postoperatively, vitreous echodensity decreased by 55%, 51%, and 52%, whereas contrast sensitivity improved by 37%, 48%, and 43% in multifocal, monofocal, and phakic eyes, respectively, suggesting good efficacy across all cohorts. The NEI Visual Function Questionnaire also demonstrated improved visual well-being for all patients. Compared to YAG laser vitreolysis, Delaney et al found that PPV was more efficacious and resulted in complete resolution of symptoms in 93.3% of eyes compared to only 38.3% following YAG laser.6 Regardless, it is important to consider the potential risks of PPV, including retinal tears and detachments, postoperative infection, and hypotony when considering this intervention.

In summary, presbyopia-correcting IOLs today offer patients a greater range of vision and rate of spectacle independence than ever before, but optimal visual quality requires a healthy visual system from the front to the back of the eye. We now know that vitreous clarity plays an important role in the patient’s postoperative quality of vision, especially in eyes implanted with presbyopia-correcting IOLs, with which the slightest aberrations can have a large impact. It is important not to dismiss patients’ complaints and to keep the vitreous in mind when evaluating the unhappy postoperative patient to better diagnose this elusive entity and offer an effective solution. Ultimately, identifying and addressing the root of the problem can help to avoid an unnecessary IOL exchange and allow patients to retain and enjoy the benefits of their presbyopia-correcting IOL.
In the future, ongoing developments promise more informative and objective diagnostics, as well as safer and more effective noninvasive therapeutic strategies to prevent and treat vision degrading myodesopsia in our cataract patients. ■
References
- Gibbons A, Ali TK, Waren DP, Donaldson KE. Causes and correction of dissatisfaction after implantation of presbyopia-correcting intraocular lenses. Clin Ophthalmol. 2016;10:1965-1970.
- Woodward MA, Randleman JB, Stulting RD. Dissatisfaction after multifocal intraocular lens implantation. J Cataract Refract Surg. 2009;35(6):992-997.
- Sebag J. Vitreous and vision degrading myodesopsia. Prog Retin Eye Res. 2020;79:100847.
- Nguyen JH, Yee KMP, Nguyen-Cuu J, Mamou J, Sebag J. Vitrectomy improves contrast sensitivity in multifocal pseudophakia with vision degrading myodesopsia. Am J Ophthalmol. 2022;244:196-204.
- Tsai WF, Chen YC, Su CY. Treatment of vitreous floaters with neodymium YAG laser. Br J Ophthalmol. 1993;77(8):485-488.
- Delaney Y, Oyinloye A, Benjamin L. Nd:YAG vitreolysis and pars plana vitrectomy: surgical treatment for vitreous floaters. Eye (Lond). 2002;16(1):21-26.
- Roufail ED, Polkinghorne P. Vitreous floaters. Compr Ophthalmol Update. 2006;7(4):171-177.
- Souza CE, Lima LH, Nascimento H, Zett C, Belfort R Jr. Objective assessment of YAG laser vitreolysis in patients with symptomatic vitreous floaters. Int J Retina Vitreous. 2020;6:1.
- Shah CP, Heier JS. YAG laser vitreolysis vs sham YAG vitreolysis for symptomatic vitreous floaters: a randomized clinical trial. JAMA Ophthalmol. 2017;135(9):918-923.
- Zhou I, Thakur S, Zhu D. Outcomes of Yag laser vitreolysis in pseudophakic eyes with visually significant opacities following cataract surgery. Paper presented at: Annual meeting of the American Society of Cataract and Refractive Surgery; May 5-8, 2023; San Diego, CA.








